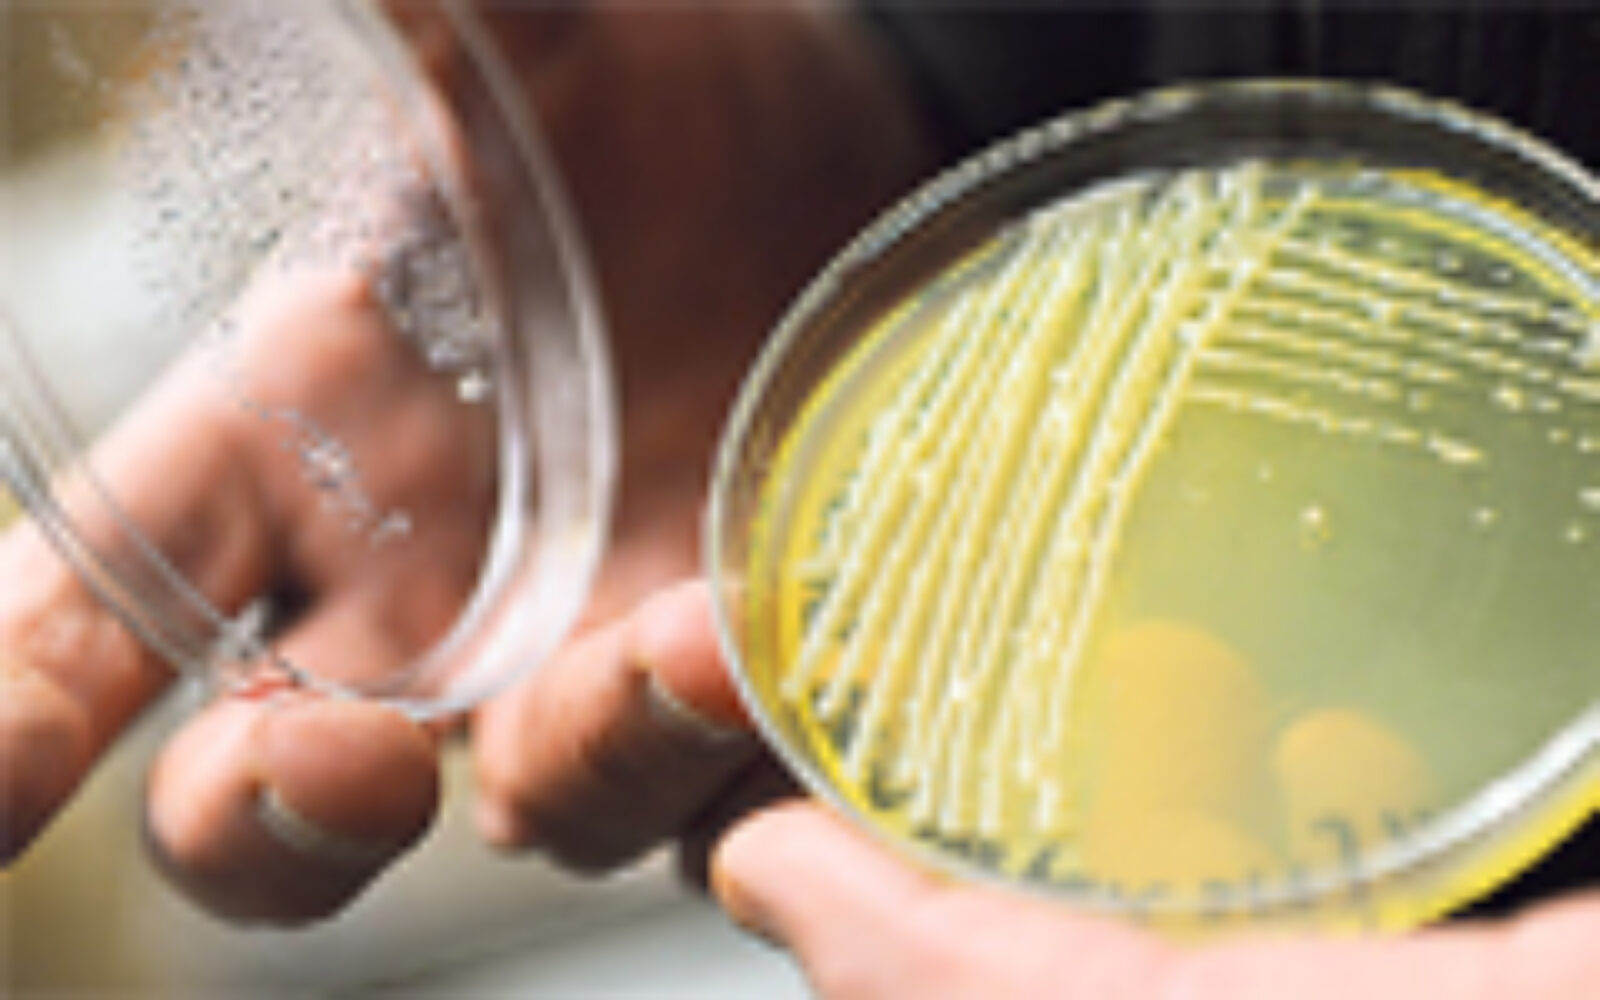

Poslovni.hr
U potrazi za energetskom injekcijom
“Buši, mala, buši!” bio je jedan od najupečatljivijih slogana republikanaca tijekom predsjednike kampanje 2008. godine, naročito drag Sari Palin. Bio je to sjajan izraz njezina domoljubnog neodobravanja ideje da se odmaknemo…